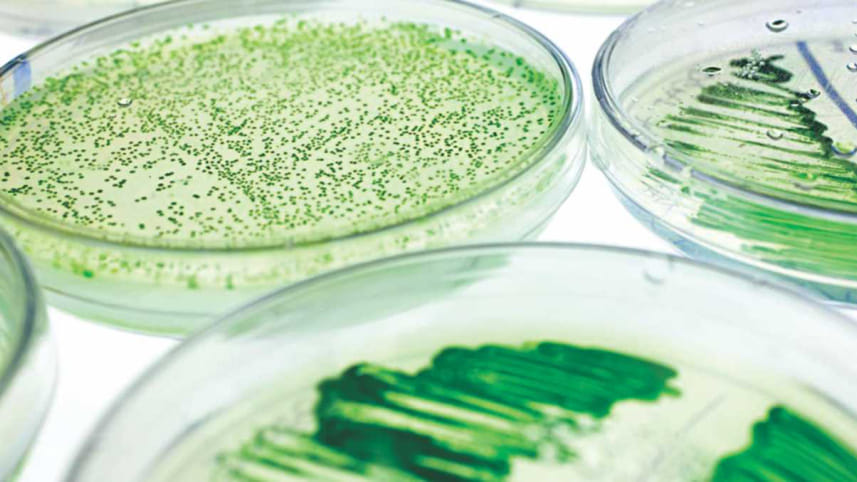
biomass.jpg

The green gold of Bangladesh: Microalgae Biomass
With a population growth of nearly 1.38%, Bangladesh will have 200 million inhabitants by 2050, which will lead to national challenges in terms of food and energy supply, as well as overall sustainability. Bangladesh has been ranked a lower-middle income country for its improved economic performance in the past year according to the World Bank. The rate of economic growth will lead to attaining the status of a higher-middle income nation within the next couple of years. Hence, food and energy need to be not only sustained but also greatly enhanced for uplifting the population and economy. According to the Bangladesh Bureau of Statistics (BBS), the country has achieved near self-sufficiency in food grain production but is far behind in energy production and supply. Think-tank economists postulate that, because of population and income growth, the demand for energy is expected to rise by over 1.3% per annum for the next few decades. Records of energy import data for the last decades indeed imply that, on average, Bangladesh imports about 3.9 million tons of petrochemicals yearly, of which diesel accounts for 2.3 million tons and costs around USD 570 million.
Policy makers and researchers in many countries have been looking for alternatives to fossil oil, and bio-fuel is one of the promising options. For several years, microalgae (in Bangla Shobuj Soibal or Seola) has been mentioned as a promising candidate for the sustainable production of feed, fuels and chemicals, and is being extensively investigated in developed countries. Microalgae, the small microorganisms, can grow in fresh, marine, waste and saline water. When grown photoautotrophically and outdoors, microalgae consume sunlight and CO2 in natural day–night cycles. They can thus be considered 'microplants' and their products can simply be labelled as vegetable products
Similar to other plants, they are a potential source of edible protein, carbohydrate, and lipids. Many species produce lipids in the form of triacylglycerol (TAG), with fatty acid compositions similar to vegetable oils, and some produce the high-value fatty acids eicosapentaenoic acid (EPA), docosahexaenoic acid (DHA), vitamins other food supplements. Spirulina powder has been used in our county for a long time. Therefore, microalgae are an interesting option for sustainable production of biodiesel and natural edible oils for bulk and specialty applications in foods and pharmaceuticals.
Microalgae, with a rich biodiversity of over 50,000 species, exist all over the world. In case of Bangladesh, no updated data is available as we do not have a national microalgae collection and culture centre. However, a total of 200 marine algal taxa (seaweeds) have been reported so far, by several Bangladeshi researchers. The government needs to setup a microalgae collection and culture centre to collects the strains and preserve the utilisation right of the country.
For this ambitious effort to be meaningful beyond the scientific community, significant investments will have to be arranged in measuring algae performance under a specific range of conditions. As we have a limitation of experts and funds, we can make international collaboration to accomplish the projects. Genomes of 186 Bangladeshi rice varieties have been sequenced in Beijing Genomics Institute, China as part of a global collaborative project in recent years, opening up new opportunities for varietal developments rice and now we can do the same for microalgae. Bill and Melinda Gates Foundation, and the Chinese Ministry of Science and Technology jointly funded the sequencing and the initial analysis for Bangladesh Rice Research Institute (BRRI). Similar projects for microalgae collections, culture, and research will give us a green economy and it will be considered the green gold of Bangladesh.
Strategies for proper management and utilisation of fresh and marine water resources need to be finalised and organisations or individuals need to be encouraged to increase investment. The government can take incentives to welcome Bangladeshi researchers across the world and give them partial or full attachments in various research institutes and universities and industries to engage their knowledge for the country.
The amount of sunlight we get is sufficient in for microalgae production. Records from the Ministry of Agricultural data show that we have 0.73 million hectares of land that are not suitable for any crop production and can be used for algae production. The water required for microalgae can be used from any source, even the waste water from our industrial or domestic use. The waste water already contains nitrogen or phosphate for algae nutrient thus this can minimise the production cost as well as mitigate the environment pollution.
Producing 1 ton of algae biomass requires 1.83 ton of CO2. Microalgae culture system can be incorporated with the power plant flue gas in case of commercial production, which will reduce air pollution and also minimise the cost of the algae production. To combat the national food and energy challenge, we need to focus on alternative sources, of energy. Microalgae is one of the strong candidates. Multilateral co-operation is needed among the government, stakeholders, researchers and individuals to make it happen.
The writer is a microalgae biotechnologist and renewable bioenergy researcher, currently affiliated with Guangzhou Institute of Energy Conversion, Chinese Academy of Science, China. He can be reached at alam@ms.giec.ac.cn



 For all latest news, follow The Daily Star's Google News channel.
For all latest news, follow The Daily Star's Google News channel.
Comments